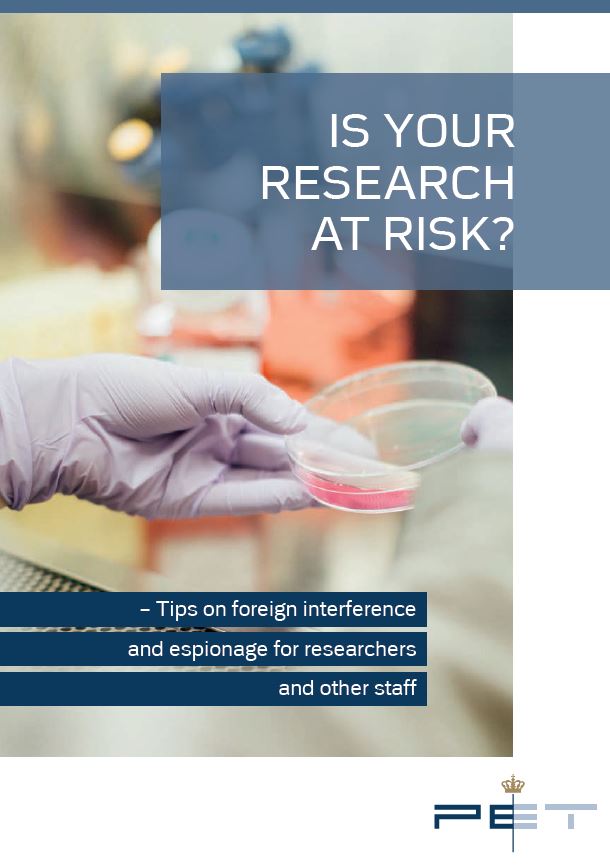
Tips on foreign interference and espionage for researchers and other staff.

-

Strategic Priorities for Research and Innovation 2026–2029
The publication outlines the Danish government's strategic priorities for research and innovation for the period 2026-2029.
-

Strategy for space research and innovation
National priorities for Danish space research, innovation and technology development 2025-2035.
-

Strategy for Quantum Technology: Part 1 – World-Class Research and Innovation
This publication constitutes the first part of a National Strategy for Quantum Technology, which can prepare Denmark for developing and applying quantum technology.
-

Denmark's national space strategy
The government has updated Denmark's space strategy with five new objectives.
-

Denmark's national space strategy executive summary
The government has updated Denmark's space strategy with five new objectives.
-
Is your research at risk?
Tips on foreign interference and espionage for researchers and other staff.
-

Green solutions of the future - Strategy for investments in green research, technology, and innovation
The Government has published Denmark’s first national strategy for investments in green research, technology, and innovation.
Search the archive
